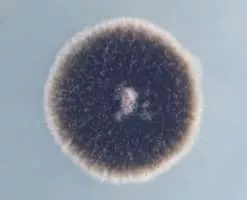

Alternaria
| Use attributes for filter ! | |
| Class | Dothideomycetes |
|---|---|
| Order | Pleosporales |
| Scientific name | Alternaria |
| Rank | Genus |
| Higher classification | Pleosporaceae |
| Division | Ascomycota |
| Date of Reg. | |
| Date of Upd. | |
| ID | 1177769 |
About Alternaria
Alternaria is a genus of ascomycete fungi. Alternaria species are known as major plant pathogens. They are also common allergens in humans, growing indoors and causing hay fever or hypersensitivity reactions that sometimes lead to asthma.